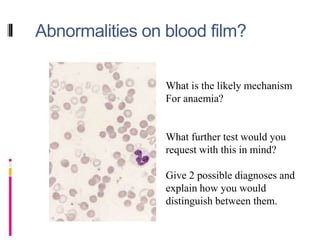
Abnormalities on blood film?
What is the likely mechanism
For anaemia?
What further test would you
request with this in mind?
Give 2 possible diagnoses and
explain how you would
distinguish between them.

Anaemia is defined as a low blood haemoglobin level below the normal range based on age and sex. Common causes include iron, folate or B12 deficiency, bleeding, bone marrow disorders, and haemolysis. Clinical features depend on severity and cause, and may include fatigue, palpitations, and signs of heart failure in severe cases. A combination of blood tests, medical history, and physical examination can help identify the underlying cause.